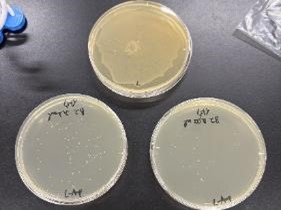
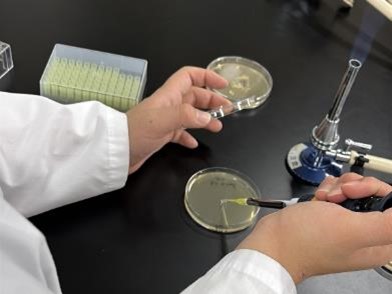
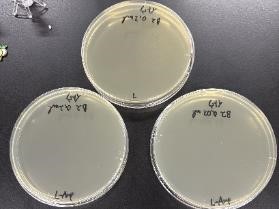
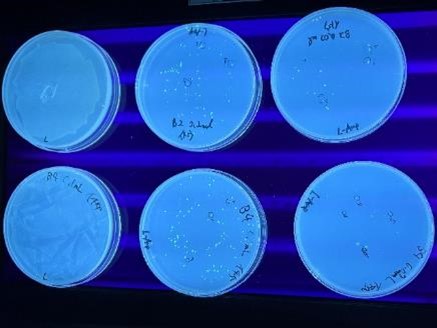

2025年9月20日(土)・21日(日)の2日間、「高校生のためのバイオサイエンスキャンプ in 長浜~大学での研究体験を仲間と楽しもう!~」に本校科学工学科の生徒2名が参加しました。このプログラムは、長浜市が主催し、長浜バイオ大学の協力のもと、株式会社リバネスが企画・実施する「学びの実験室NEXT 産官学連携プロジェクト」の一環として行われたものです。
プログラムでは3つの分野に分かれて、研究体験をしました。
以下は、「電子顕微鏡で植物を観察・分類しよう!」参加者によるレポートです。
1日目では長浜バイオ大学から徒歩15分ほどの所にある田村山という山に足を運び特徴的な草や虫を採取し、大学に持ち帰り同定を行いました。植物の同定は昆虫や動物に比べ特徴の違いがわかりづらく難しいと感じました。
2日目では同定を行った植物の中から特に特徴的なものを数個選び電子顕微鏡で観察しました。そして、その結果を元に考察を経て発表スライドを作りプレゼンテーションを行いました。普段触れることの無い電子顕微鏡を実際に使い細部まで観察することなどの新鮮な経験をすることが出来ました。
この経験を活かし、今後は身近な自然の中にも新たな発見の視点を持ち観察力や分析力をさらに磨いていきたいです。
このプログラムの中で普段なら関わることの無い分野を知ることができ、成長を感じられる有意義な2日間でした。長浜市, 株式会社リバネス, 長浜バイオ大学の皆さま、また、その他の関係者の皆さまありがとうございました。



以下は、「遺伝子組み換えで光る大腸菌をつくろう!」を体験した生徒のレポートです。
今回の研究体験では大腸菌を用いて「形質転換」について学びました。
大腸菌(Escherichia coli)は興味深い遺伝的特徴を持ちます。本体に相当する染色体DNAには細胞に必要な基本的な設計図が含まれています。一方、付加的な小さな環状DNAであるプラスミドは、耐性や発現用遺伝子など可変的な遺伝情報を運ぶことがあります。
1日目は、外来DNA(プラスミド)を大腸菌に導入する形質転換を体験しました。
大腸菌のコンピテントセルに、アンピシリン耐性を持つpUC18プラスミドと、緑色蛍光タンパク質(GFP: Green Fluorescent Protein)を発現させるpGFPuvプラスミドをヒートショック法で導入しました。
導入後の細胞はLB寒天培地およびアンピシリン含有LB寒天培地(L-amp)に塗布しました。
2日目は、形質転換に成功したコロニーの観察と解析を行いました。
L-amp寒天培地上のコロニーから菌懸濁液を作製し、DNAを抽出してGFP特異的プライマーを用いたPCR(ポリメラーゼ連鎖反応)を行い、アガロースゲル電気泳動によりGFP遺伝子の有無を判定しました。
増幅産物をアガロースゲル電気泳動で分離・確認することで、GFP遺伝子の有無を確かめました。
PCRでGFP遺伝子の存在が確認できたコロニーについて、紫外線下でGFP蛍光を観察し、導入遺伝子が機能していることを最終確認しました。 このように、アンピシリン選択で“形質転換株”を一次選抜し、PCRで“GFP遺伝子保持株”を二次選抜、蛍光観察で“発現の有無”を最終確認するという段階的なアプローチを学びました。
以上の体験を通して、ヒートショックによる形質転換やアンピシリン選択、紫外線下でのGFP観察など、教科書で学んだ手順が「目に見える結果」に結びつくことが印象的でした。さらに、PCRとアガロースゲル電気泳動による確認は、観察だけでは分からない遺伝子配列の存在を裏付け、複数の手法を組み合わせて結論を導く科学の基本を体感させてくれました。また、多くの資料や記念品をいただきました。
最後に、高校生のためのバイオサイエンスキャンプin長浜の開催にあたり、企画・運営してくださった株式会社リバネスの皆様、実験を補助してくださった長浜バイオ大学の皆様、ならびに開催にご協力いただいた長浜市の皆様に心より感謝申し上げます。

Comments are closed